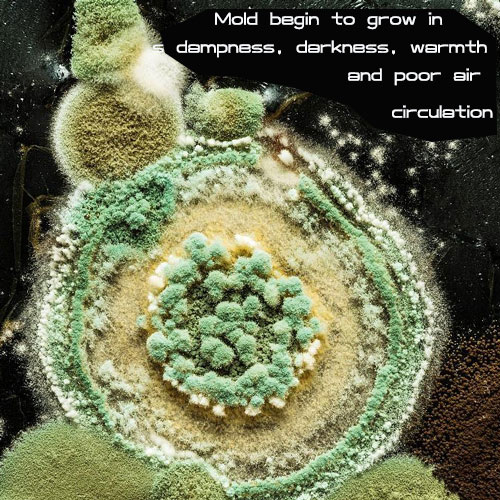
The picture of mold

I. Understanding Mold
Mold is a fungus that spreads its spores into the air as they mature, and will begin to grow when it encounters dampness, darkness, warmth, and poor air circulation, i.e.
II. Mechanism of killing molds by trisodium phosphate
Trisodium phosphate is a broad-spectrum fungicide, and its disinfection mechanism is mainly through the inhibition of respiration and enzyme activity of diseased molds, destroying the integrity of the cell membrane, thus killing the pathogenic bacteria. Trisodium phosphate can dissolve the cell membrane of the mold, causing the loss of cell contents, resulting in the death of the mold.

III. Application Examples
A. Wall Mold Cleanup
In the higher temperature and wet conditions for painting the wall, the wall will often appear black and gray mold, which is caused by the growth of wall mold. To remove the mold, can use 7%-10% of industrial trisodium phosphate aqueous solution sprayed 1-2 times, scrape and clean the mold position.

B. Clean the mold growing on wood, painted surfaces, tiles, etc.
Clean with a solution made from ½ cup of cleaner containing trisodium phosphate, ½ cup of regular cleaner, and ½ cup of bleach with 3.8 liters of water.

In these cleaning cases, you could either use trisodium phosphate cleaner or other mold cleaners with trisodium phosphate as one of the ingredients.
C. Sterilization of seeds
Trisodium phosphate can be used to disinfect seeds by spraying and soaking.
In the specific application process, the disinfection method should be flexibly selected according to the different crops and the severity of the disease. For more serious diseases, the soaking method can be used to soak the seeds in trisodium phosphate solution for a period of time to achieve the effect of complete disinfection.
For mild diseases, disinfection can be carried out by spraying trisodium phosphate solution to achieve a rapid sterilization effect.

IV. Precautions
When using trisodium phosphate to kill molds, it should be noted that the concentration used should be appropriate and should not be too high or too low, otherwise its disinfection effect will be affected. Secondly, seeds need to be cleaned before disinfection so as not to affect the disinfection effect.
V. Conclusion
Trisodium phosphate is a broad-spectrum fungicide that dissolves the cell membranes of pathogens, causing the loss of cellular contents and resulting in the death of the mold. Therefore its aqueous solution kills mold on walls, wood, painted surfaces, tiles, and seeds. The concentration of the solution needs to be careful, too high or too low will affect the effect. Of course, using as mold cleaner is just one of the trisodium phosphate uses. It also have a lot of applications in the household and industry. Along with the research of this chemical and scientist development, we believe there will be more and more interesting uses for this chemical.